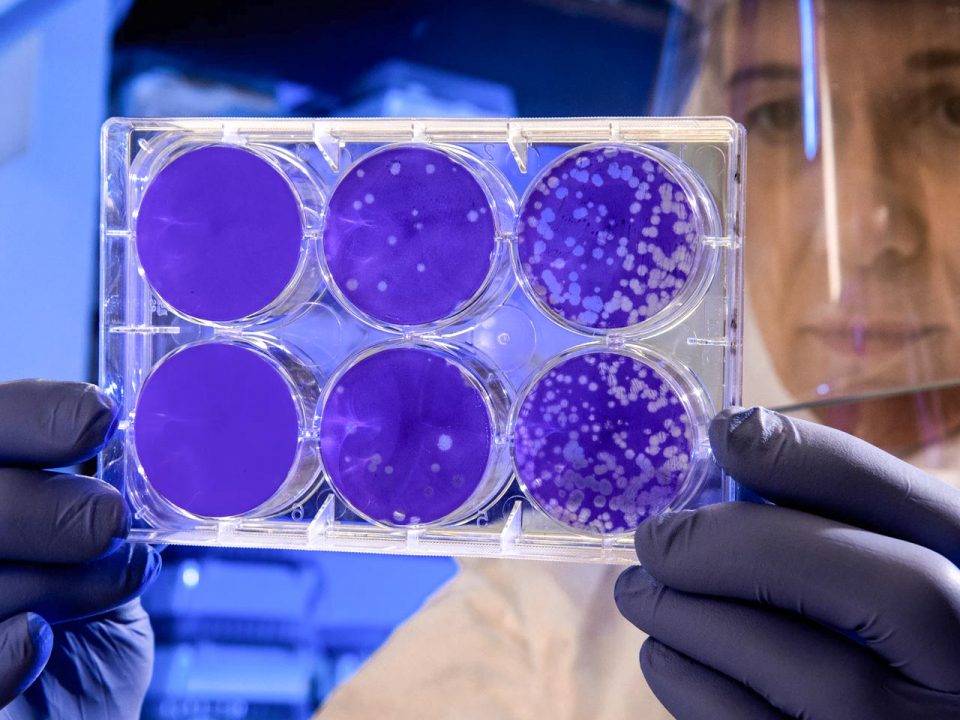

April 23, 2020

What’s new.
Keep up to date with the latest news
- All
- Adventures
- Agency
- Aliquam
- Apple
- Applications
- Art
- Audio
- Bez kategorii
- Business
- Camera
- Chemistry
- Collaboration
- Computers
- DESIGN
- Entertainment
- Events
- Gaming
- Gastronomy
- Gear
- Geography
- Guides
- Integer
- Languages
- Laptop
- Law
- Lorem
- Mathematics
- Microsoft
- Movie
- Music
- News
- Nulla
- Photography
- Physics
- Places
- PRODUCTIVITY
- Programming
- Quisque
- Resources
- Review
- Security
- Shopping
- Smartphone
- Sport
- Uncategorized
- WORKFLOW
April 23, 2020
April 23, 2020
April 23, 2020
April 23, 2020
April 22, 2020
April 22, 2020
April 20, 2020
April 16, 2020